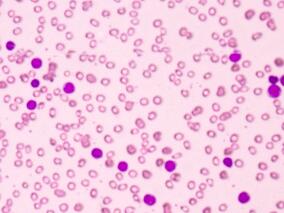
新确诊BCR-ABL阳性ALL：基于伊马替尼化疗的疗效

-
血液系统恶性肿瘤患者:伏立康唑超治疗血药浓度是否…
环球医学资讯
2017年06月20日
点击量:563
1小时条评论无神经系统毒性症状的血液系统恶性肿瘤合并超治疗伏立康唑血药浓度患者之后发生中枢神经系统毒性几率如何?2017年6月,发表在《Clin Microbiol Infect.》的一项研究对此进行分析。 目的:研究者考察了伏立康唑(VRC)水平升高但无临床显著中枢神经系统(CNS)毒性的...
-
依维莫司治疗复发或难治性惰性淋巴瘤疗效如何?
环球医学资讯
2017年06月16日
点击量:403
1小时条评论复发性惰性淋巴瘤通常会对化学免疫疗法产生耐药,需要新的疗法来治疗。靶向多种类型淋巴瘤PI3K/mTOR通路的疗法已经显示出临床前和临床疗效,为检验复发性/难治性惰性淋巴瘤治疗策略提供了理论基础。2017年5月,发表在《Am J Hematol》的一项研究调查了口服mTORC1抑制...
-
新确诊BCR-ABL阳性ALL:基于伊马替尼化疗的疗效
环球医学资讯
2017年06月16日
点击量:203
1小时条评论2017年4月,发表在《Am J Hematol》的一项II期试验考察了基于伊马替尼的疗法与强化巩固治疗在费城染色体(Ph)阳性急性淋巴细胞白血病(ALL)患者中的有效性,以预防早期复发。 研究者开展了一项针对新确诊BCR-ABL 阳性成人ALL 患者伊马替尼联合化疗的II期试验。200...
-
癌症住院患者静脉血栓栓塞风险:KS预测工具是否有效?
环球医学资讯
2017年06月16日
点击量:461
1小时条评论静脉血栓栓塞(VTE)是一种需要住院患者重点预防的疾病;癌症的风险多样,而预防是一致的。既往证实的工具(Khorana评分,[KS])由5个容易获得的变量组成,可以确定门诊癌症患者的VTE风险,但该工具尚未在住院患者中研究过。2017年6月,发表在《Am J Hematol》的一项...
-
抗凝治疗过程中与肿瘤相关的胃肠道大出血有哪些特征?
环球医学资讯
2017年06月15日
点击量:666
1小时条评论2017年5月,发表在《Clin Gastroenterol Hepatol》的一项系统评价,比较了肿瘤相关的胃肠道大出血事件(MBGI)与非恶性肿瘤或不明来源的MBGI的特征。 背景和目的:接受抗凝药物的胃肠道(GI)出血患者可能是由隐匿的恶性肿瘤引起的。研究人员考察了接受抗凝治疗的患...
-
想改善行结直肠癌肝转移切除术后的结局?快用贝伐单…
环球医学资讯
2017年06月08日
点击量:391
1小时条评论肝切除术是结直肠癌肝转移(CRLM)患者的重要选择。尽管未有随机试验证明,但CRLM切除术比化疗效果好。2017年6月,发表在《Br J Surg》的一项研究,考察了术前接受贝伐单抗对结直肠癌肝转移的肝切除术中切缘状态的预后影响。 背景:在引入生物化疗前的几年,CRLM切...
-
癌症患者代谢亢进影响恶液质和生存期!
环球医学资讯
2017年06月08日
点击量:805
1小时条评论2017年5月,发表在《Am J Clin Nutr》的一项前瞻性研究,考察了癌症患者代谢亢进、恶液质和生存期之间的关系。 背景:恶液质是癌症患者的主要死亡原因。代谢亢进在癌症患者恶液质中的作用仍然未知。 目的:旨在研究静息能量消耗(REE)、估计能量平衡、恶液质的临...
-
惰性非霍奇金淋巴瘤:LR-CD方案效果如何?
环球医学资讯
2017年06月05日
点击量:276
1小时条评论2017年5月,发表在《Am J Hematol》的一项由美国和加拿大科学家进行的II期研究,考察了来那度胺、利妥昔单抗、环磷酰胺和地塞米松(LR-CD)治疗未经治疗的低恶性度非霍奇金淋巴瘤的可行性、有效性和安全性。 惰性非霍奇金淋巴瘤(NHL)患者有多种治疗选择,但最佳初...
-
AML老年患者:标准诱导治疗添加克拉屈滨很给力!
环球医学资讯
2017年06月05日
点击量:550
1小时条评论2017年4月,发表在《Am J Hematol》的由波兰和英国科学家进行的波兰成人白血病组(PALG)II期试验表明,急性髓系白血病(AML)老年患者标准诱导治疗中添加克拉屈滨可改善结局。 使用蒽环类抗生素和阿糖胞苷的强化诱导治疗被视为身体健康的AML老年患者最有效的前沿疗...
-
BCL2突变是否导致利妥昔单抗治疗的滤泡性淋巴瘤患者…
环球医学资讯
2017年06月05日
点击量:301
1小时条评论2017年6月,发表在《Am J Hematol》的一项由法国和美国科学家进行的研究表明,BCL2突变不会导致利妥昔单抗治疗的滤泡性淋巴瘤(FL)患者预后不良。 已有研究表明,BCL2突变会导致FL患者预后不良,但预后值并没有在接受含利妥昔单抗方案治疗的患者中评价过。在此,研...

会员登录

